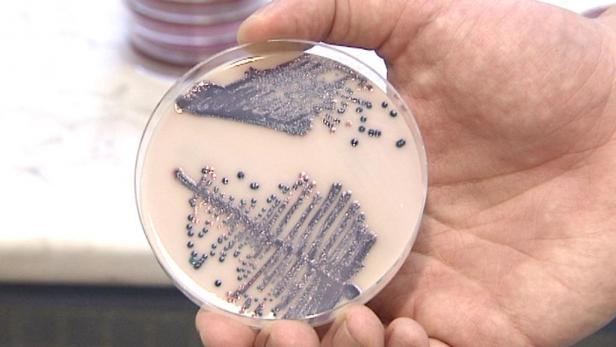

据英国广播公司5月14日报道,比利时研究人员通过研究一种肠道细菌发现,含有这种细菌的液体培养基能大大改变肥胖老鼠的健康状况。相关研究报告发表在美国《国家科学院院刊》(PNAS)上。
比利时鲁汶天主教大学的研究人员给比正常老鼠的脂肪多两至三倍的老鼠喂了一种被称为Akkermansia muciniphila的细菌,在不改变其饮食的情况下,它们的多余体重减少了近一半,而且其体内II型糖尿病的主要症状——胰岛素抗体水平——也降低了。
这种细菌通常占肠道细菌的3-5%,但肥胖者体内这种细菌少。研究显示,增加这种细菌导致肠道粘液屏障变厚,从而阻止某些物质从肠道进入血液,也改变了来自消化系统的化学信号,促使身体其他部位改变处理脂肪的方式。
此外,在食物中添加一种纤维,促使这种细菌数量增加,也得到了同样的结果。
鲁汶天主教大学教授帕特里斯 卡尼说:“这无疑是个进步。虽然我们还不能完全逆转肥胖,但大大减少了脂肪量。这首次显示了一个特定菌群与改善新陈代谢之间的直接联系。”
卡尼教授表示,肠道中有数千种细菌,却只有一种能产生这样的效果,这一发现“令人惊讶”。他说,这是迈向“最终使用这种细菌预防或治疗肥胖症和II型糖尿病的第一步。”在“不远的将来”,某种基于细菌的疗法将会投入使用。
科克大学微生物学家科林 希尔教授说,“这是非常令人兴奋的研究,我们早就发现细菌与体重增加有关,但这是首次一种干预似乎起作用。”
“我认为这样不行:你一整天都吃奶油蛋糕、炸薯条和香肠,然后吃细菌来改变一切。”他认为,该研究更有可能引导人们了解肠道到底发生了什么,从而为试图减肥的人量身定制饮食建议。
